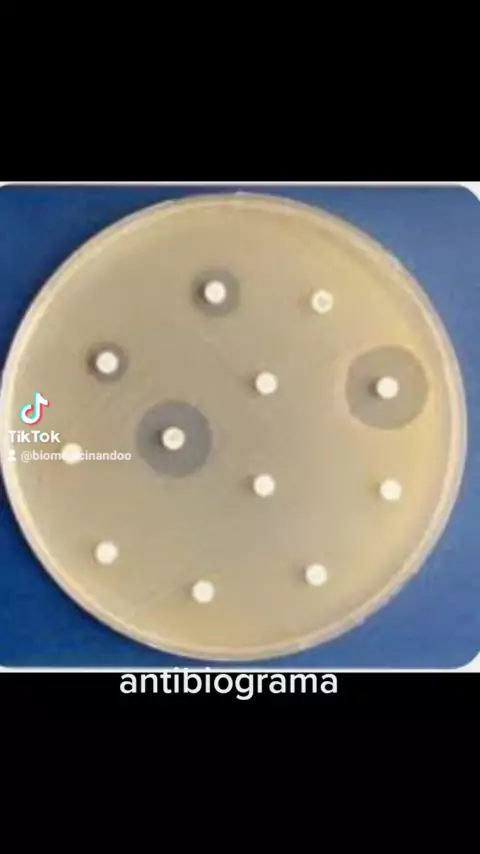

Ikuti
23
0
15
repostes de vídeos biomedicina
quando há um crescimento bacteriano é feito um atibiograma que é útil para verificar quais os antibióticos poderão ser usados para tratar aquela infeção com maior chance de sucesso #biomed #biomedicina #MICROBIOLOGIA
Lebih banyak
Komentar
Batal
Kirim